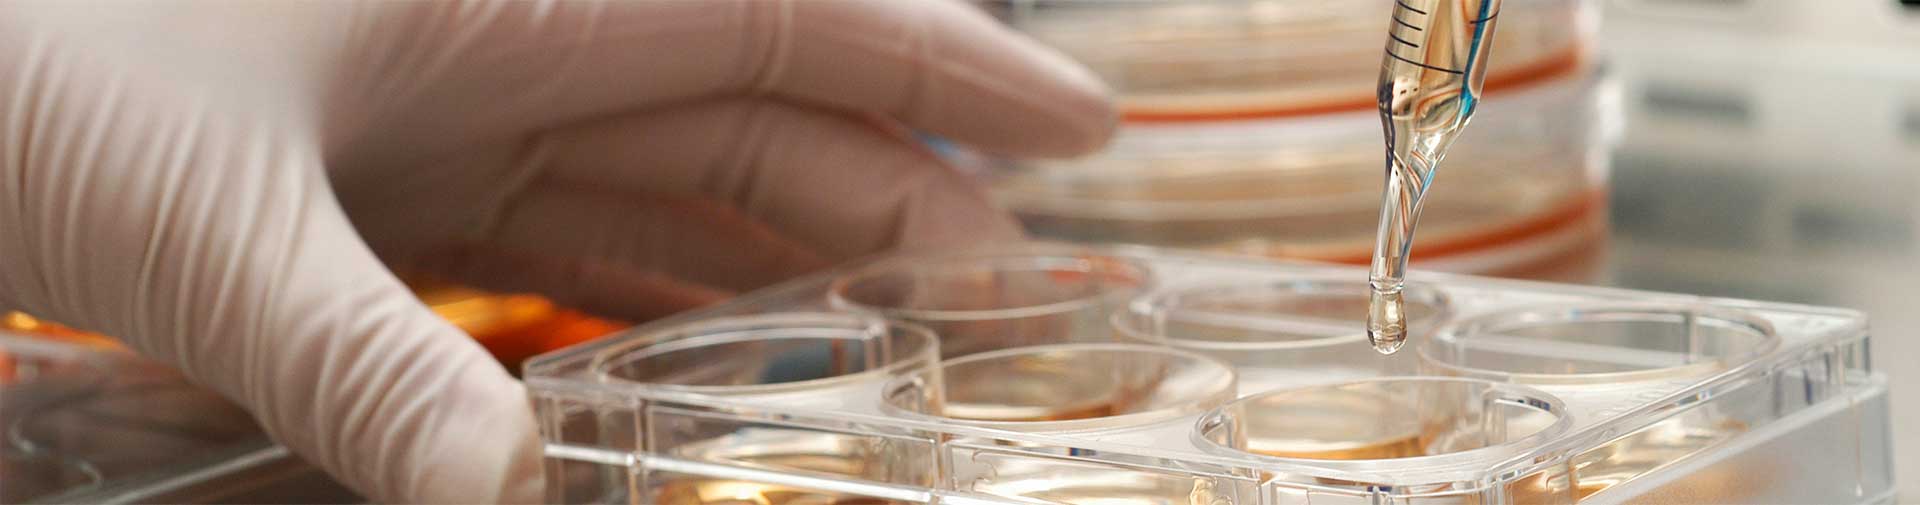

Food / Pharma Raw Material
Our Commitement to excel in healthcare business is reflected in our strong product line that we source from WHO-GMP, USFDA certified principles, process-led, we follow international best practises in making safe, cost-effective, real-time deliveries to our clients.
Active Pharma Ingredients
Analgesic / Neuropathic Pain
Anti Allergics
Antibiotic / Antibacterial
Antifungal / Antiprotozoal
Gastro-intestinal Drugs
CNS Drugs
Fertility Agents
Muscle relaxant
Anthelmintic
Anti-Cancer
Antidiabetics
Cardiovascular
Gluconate
Iodides & Citrates(Salts)
Iron Salts
Vitamins
Others
“Welcome to check with us for your pharmacopoeia specification & any other materials not listed above.”
Analgesic / Neuropathic Pain
- Bromfenac Sodium
- Bupropion Hydrochloride
- Dexketoprofen Trometamol
- Gabapentin
- Ibudilast
- Licofelone
- Mefenamic Acid
- Meloxicam
- Nepafenac
- Phenylbutazone
- Pregabalin
- Roflumilast
Anti Allergics
- Alcaftadine
- Arformoterol tartrate
- Cetrizine Di HCl
- Chlorpheniramine Maleate
- Desloratadine
- Dexchlorpheniramine Maleate
- Diphenhydramine HCl
- Emedastine difumarate
- Emedastine difumarate
- Montelukast sodium
- Olopatadine hydrochloride
- Pheniramine Maleate
- Rupatadine fumarate
Antibiotic / Antibacterial
- 2 Phenoxy Phenyl Methane Sulfonemide
- Azithromycin
- Besifloxacin Hydrochloride
- Chloramphenicol
- Chloramphenicol Palmitate
- Enrofloxacin Base
- Lymecycline
- Moxifloxacin Hydrochloride
- Nalidixic Acid
- Norfloxacin
- Sulfacetamide
- Sulfacetamide Sodium (DRC)
- Sulfanilamide
- Sulfathiazole
Antifungal / Antiprotozoal
- Econazole Nitrate
- Fluconazole
- Miconazol Nitrate
- Nitazoxanide
- Ornidazole
Gastro-intestinal Drugs
- Dicyclomine Hydrochloride
- Domperidone / Maleate
- Simethicone (Activated Dimethicone)
- Ondansetrone HCl
- Iloperidone
- Simethicone Emulsion (30%)
CNS Drugs
- Agomelatine
- Dapoxetine Hydrochloride
- Eslicarbazepine Acetate
- Fluoxetine Hydrochloride
- Fluvoxamine Maleate
- Lurasidone Hydrochloride
- Olanzapine
- Risperidone
Fertility Agents
- Chlorzoxazone
- Tamoxifen Citrate
Muscle relaxant
- Clomiphene Citrate
- Eperisone Hydrochloride
- Flavoxate Hydrochloride
- Metaxalone
- Tizanidine Hydrochloride
- Tolperisone Hydrochloride
Anthelmintic
- Piperazine Hydrate / Citrate / Adipate/ Phosphate
Anti-Cancer
- Anastrozole
- Letrozole
Antidiabetics
- Glibenclamide
- Glyburide
- Metformin Hydrochloride
- Pitavastatin Calcium
- Progunail Hydrochloride
Cardiovascular
- Atenolol
- Atorvastatin Calcium
- Clonidine
- Clonidine Hydrochloride
- Dronedarone Hydrochloride
- Ezetimibe
- Indapamide
- Losartan Potassium
- Olmesartan Medoxomil
- Rosuvastatin Calcium
- Telmisartan
Gluconate
- Calcium Glubionate
- Copper Gluconate
- Gluconic Acid (50% Solution)
- Magnesium Gluconate
- Manganese Gluconate
- Zinc Gluconate
Iodides & Citrates (Salts)
- Calcium Citrate
- Citric Acid Anhydrous
- Citric Acid Monohydrate
- Mono Sodium Citrate
- Potassium Chloride (Pyrogen Free)
- Potassium Citrate
- Potassium Iodide
- Sodium Acid Citrate
- Sodium Chloride (Pyrogen Free)
- Sodium Citrate
- Sodium Iodide
Iron Salts
- Calcium Ferrous Citrate
- Dried Ferrous Sulphate
- Ferric Ammonium Citrate
- Ferrous Fumarate
- Ferrous Gluconate
- Ferrous Glycine Sulphate
- Fumaric Acid (Technical Grade)
Vitamins
- Methly Nicotinate
- Pyrazinamide
- 4-Hexyl Resorcinol (BP, USP)
- Allantoin (BP, USP)
- Zoledronic acid
- Valproic Acid
- 4 Chloro 2 Amino Phenol
- Glycolid Acid
- Pralidoxime Iodine (PAMI IODIDE / 2 PAM)
- Bromhexine Hydrochloride B.P. / Eu. Ph.
- Tazarotene
- Argatroban
- Tranexamic acid (BP)
- Eletriptan hydrobromide
- Dalfampridine
- Alcaftadine
- Brimonidine tartrate
- Brinzolamide
- Cinacalcet hydrochloride
- Deferasirox
- Arformoterol tartrate
- Ethacrynate sodium
- Ethacrynic acid
- Strontium citrate
- Strontium ranelate
- Darifenacin Hydrobromide
- Dorzolamide hydrochloride
- Timolol maleate
- Felbamate
- Topiramate
- Tetrabenazine
- Aceturic Acid
- Benzalkonium Chloride Solution 50%
- Ethacrynate sodium
- Ethacrynic acid
- Strontium citrate
- Strontium ranelate
- Darifenacin Hydrobromide
- Eperisone hydrochloride
- Solifenacin succinate
- Tolperisone hydrochloride
- Trospium chloride
- Terazosin hydrochloride
- Agomelatine
- Pramipexole hydrochloride
- Safinamide
- Tolvaptan
- Prasugrel hydrochloride
- Clopidogrel bisulfate
- Febuxostat
- Fingolimod hydrochloride
- Teriflunomide
Others
- 4 Chloro 2 Amino Phenol
- 4-Hexyl Resorcinol
- Aceturic Acid
- Agomelatine
- Alcaftadine
- Allantoin
- Arformoterol Tartrate
- Argatroban
- Benzalkonium Chloride Solution 50%
- Brimonidine Tartrate
- Brinzolamide
- Bromhexine Hydrochloride
- Cinacalcet Hydrochloride
- Clopidogrel Bisulfate
- Dalfampridine
- Darifenacin Hydrobromide
- Deferasirox
- Dorzolamide Hydrochloride
- Eletriptan Hydrobromide
- Eperisone Hydrochloride
- Ethacrynate Sodium
- Ethacrynic Acid
- Febuxostat
- Felbamate
- Fingolimod Hydrochloride
- Glycolid Acid
- Lacosamide
- Methly Nicotinate
- Pralidoxime Iodide (Pam Iodide / 2 Pam)
- Pramipexole Hydrochloride
- Prasugrel Hydrochloride
- Pyrazinamide
- Safinamide
- Solifenacin Succinate
- Strontium Citrate
- Strontium Ranelate
- Tazarotene
- Terazosin Hydrochloride
- Teriflunomide
- Tetrabenazine
- Timolol Maleate
- Tolperisone Hydrochloride
- Tolvaptan
- Topiramate
- Tranexamic Acid
- Trospium Chloride
- Valproic Acid
- Zoledronic Acid
Excipients
- Maize Starch
- Sodium Starch Glycolate (Maize Starch Based)
- Pumojel – Sodium Starch Glycolate (Potato Starch Based)
- Palmo-Wax (Non-Ionic Emulsifying Wax
- Palpeg-200 (Polyethylene Glycol 200)
- Palpeg-400 (Polyethylene Glycol 400)
- Beeswax White/Yellow Refined Bp
- Carnauba Wax Prime Yellowish
- Magnesium Stearate
- Di Calcium Phosphate
- Light Magnesium Carbonate
- Light Magnesium Oxide
- Micro Crystalline Cellulose
- Pregelatinized Starch
- Crosscarmellose Sodium
- Palsorbate-80
- Palsorbate-60
- Emulsifying Wax Non Ionic
- Emulsifying Wax Anionic
- Petroleum Jelly White
- Paraffin Wax Fully Refined
- Micro Crystalline Wax
“Welcome to check with us if your required Excipients materials are not listed”
Fine Chemicals
- Salicylanilide
- Para Bromo Toluene 99.5%
- Pyridine Hydrobromide
- Potassium Phthalimide
- Nicotinic Acid Hydrazide
- 3 Amino Pyridine
- Methyl Iodide
“Welcome to check with us if your required Fine Chemical materials are not listed”
Intermediate
- œ-Phenyl – 2 – Pyridyl Acetonitrile / œ-Phenyl – 2 – Pyridyl Acetamide
- 1-(3-Chloropropyl) – 1, 3 Dihydro-2h-Benzimidazolone
- 1,2,3,9 Tetrahydro-4-H-Carbazole-4-One
- 9. Methyl-1,2,3,9- Tetrahydro-4-H- Carbazole-4-One
- Dimethyl Amino Propyl Chloride HCl
- 2,3, Dimethoxy – 5 Methyl-Benzo-1, 4, Quinone
- 3-Dimethyl Amino – 1- (2-Thienyl) -1 – Propanone HCl
- Rs-N-N-Dimethyl-3-Hydroxy-3-(2-Thienyl)-1-Propanamine
- 4-(3,4, Dichlorophenyl) – 3-4-Dihydro Namphthalenone (Tetralone)
- 1-Benzhydryl-4-2-(2-Hydroxyethyl) Piperazine HCl
- 1,4, Benzodioxane Carbony Piperazine HCl / Base
- 1-(3-Chloro Phenyl) – 4 – (3-Chlorophenyl) Piperazine HCl
- 1-(3-Chloro Propyl) – 4 – (2-Methoxy Phenyl) Piperazine HCl
- 4-(2-Piperidino Ethoxy) Benzoic Chloride HCl
- 4-Chloro-4′ Fluoro Butyrophenone
- 4-(2-Piperidino Ethoxy) Benzoic Acid HCl
- 2-Chloro-3-Nitro-4-Methyl Pyridine
- 2-(2 Methoxy Phenoxy) Ethyl Amin
- 4-Chloro-4′- Tert-Butyl-Butyrophenone
- N Acetyl-L-Serine Methyl Ester HCl
- 2,4- Dichloro-Phenacyl Chloride
- 4-Methoxy Phenacyl Bromide
- 4-Benzoyloxy-3-Nitrophenacyl Bromide
- Di – P- Anisoyl – L – Tartaric Acid
- 3-Benzoyloxy-Phenacyl Bromide
- 4-Chloro Phenacyl Bromide
- 4-Methyl Phenacyl Bromide
- Di – P- Anisoyl – L – Tartaric Acid
- 4-Chloro Benzhydryl Piperazine
- N-(4-Methoxy Phenyl) Piperazine
- N- Benzyl Piperazine 2HCl
- N-(4-Hydroxy Phenyl) Piperazine
- 1-(3-Chloro Phenyl) Piperazine Base/HCl
- 1-(2,3, Dichloro Phenyl) Piperazine HCl
- 4′ – 4′ – Difluoro Benzhydryl Piperazine
- Di Benzoyl-D-Tartaric Acid Monohydrate
- Di Benzoyl-L-Tartaric Acid Monohydrate
- D-Tartaric Acid Mono P-Nitro Anilide
- L-Tartaric Acid Mono P-Nitro Anilide
- L-Tartaric Acid Mono P- Chloro Anilide
- D – Tartaric Acid Mono P – Chloro Anilide
- 3-Methyl-Thiophene-2-Aldehyde
- Racemic Sertraline
- Phthalazine
- 2,6, Dipicolinic Acid
- Thiophen-2-Aldehyde
- Diphenyl Acetonitrile
- 3,4, Dimethoxy Tolune
- 4-Bromo Phenol
- 4-Bromo Anisole
- Benzhydryl Bromide
- Tetrahydro Pyrimidine
- 2-Chloro Pyrimidine
- Diphenyl Acetic Acid
- Benzhydryl Piperazine
- N-Cyclohexyl Piperazine
- N-(2-Furoyl) Piperazine
- Di P-Toluoyl-D-Tartaric Acid
- Di P-Toluoyl-L-Tartaric Acid
- Di-P-Anisoyl-D- Tartaric Acid
- 2-Methyl-3-Nitro Phenyl Acetic Acid
- 3-Amino Propyl Chloride HCl
- L-Tartaranilic Acid
- D- Tartaranilic Acid
- 4-(4-Chlorophenyl)- 4 – Hydroxy Piperidine
“Welcome to check with us if your required Intermediate materials are not listed”
 En
En Ru
Ru Ua
Ua